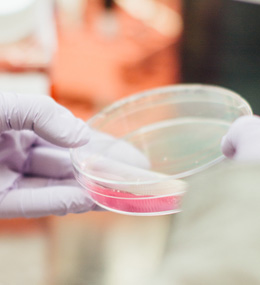
风险评估

LINKTEST Lab Technology Solutions
CMA&CNAS资质,符合国标、欧盟、FDA要求
检测范围
EXAMINATION RANGE
类别 | 检测产品 |
|---|---|
餐具 | 刀叉、碗、筷、勺、杯、碟等 |
厨具 | 贮存用具、洗涤用具、烹饪用具、调理用具、加工用具等 |
食品包装容器 | 金属容器、塑料容器、玻璃陶瓷容器、纸容器、塑料包装袋、包装膜等 |
厨房家电 | 搅拌机、榨汁机、电热水壶、咖啡机、面包机等 |
儿童用品 | 婴幼儿饮水杯、奶瓶等 |
加工设备 | 生产线管道、设备等 |
其他 | 树脂、涂料、油墨、涂层等 |
服务项目
SERVICE ITEMS
-
 合规测试中国 GB 4806系列
合规测试中国 GB 4806系列
美国 FDA 21CFR 170-189
欧盟 EU 10/2011及 指令1935/2004
德国 LFGB
法国 DGCCRF
意大利 DM Decree
澳大利亚 AS 2070
-
风险评估高关注物质风险评估
风险评估高关注物质风险评估
(双酚A,多环芳烃,矿物油等)
异物成分鉴定及来源分析 -
 供应链管理国内外法规解读、跟踪及人员培训
供应链管理国内外法规解读、跟踪及人员培训
技术文件制作、审核
方法开发,包括开发、验证、比对及培训等 -
 质量提升标准协助撰写
质量提升标准协助撰写
技术研讨
人员培养
服务详情
SERVICE DETAILS
-
GB 4806安全卫生检测
-
食品包装容器检测
-
各国食品接触检测














 立即咨询
立即咨询 留言咨询
留言咨询
 立即咨询
立即咨询
